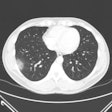
2020 11 12 22 05 2505 2020 05 15 Non Chest Ct Covid Figure 4 400

Kate Madden Yee has been reporting on medical imaging since 1998, when she started writing for Diagnostic Imaging Scan. She joined AuntMinnie.com in 2001, and continues to be fascinated by what imaging contributes not only to research but also to patient care. Kate's current beats are MRI and CT, but she has written about every modality throughout her career. She has an MFA in nonfiction writing from Penn State University and lives in the California Bay Area.